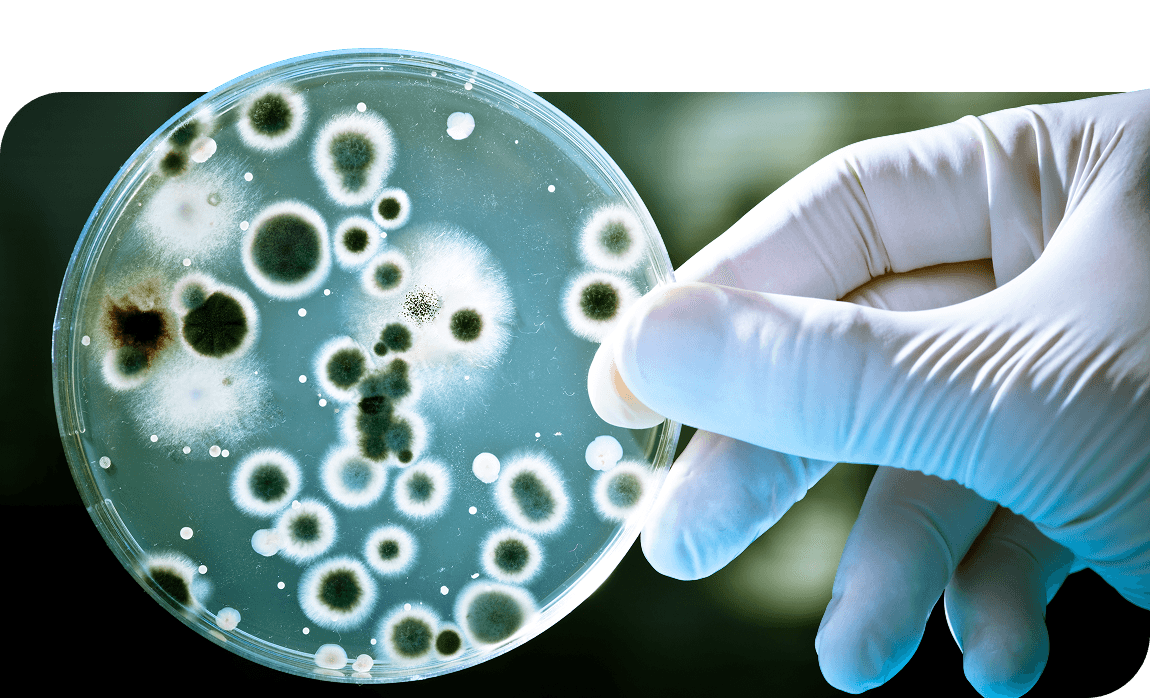
Hero Call Out

MISSION
Fueling the future of cancer research
THE TIME IS NOW
Cancer research today is often divided across separate projects. The Cancer AI Alliance (CAIA) is creating a platform that connects them. With advanced AI, researchers can study large datasets more quickly while protecting patient privacy. Using federated learning, the AI platform combines insights across centers without moving the data itself. CAIA is committed to strict ethical and regulatory standards. Our goal is to speed up discoveries that will improve cancer care and outcomes.
An era ofpossibility
More than 17 million people in the United States are living with cancer. Progress has been made—for example, five-year survival rates for prostate cancer have increased by 50% since 1975, and survival rates for leukemia and myeloma have doubled. But these advances need to become the rule, not the exception.
An era ofpossibility
More than 17 million people in the United States are living with cancer. Progress has been made—for example, five-year survival rates for prostate cancer have increased by 50% since 1975, and survival rates for leukemia and myeloma have doubled. But these advances need to become the rule, not the exception.
2M
People diagnosed in 2024
611K
Cancer-related deaths in 2024
69%
Five-year survival rate for all cancer types
Data as the key
Every patient generates valuable data with each scan, treatment, and year of survival. This information fuels AI models that can change how we understand and treat cancer. The greatest impact comes when data from millions of patients is combined. Together, these data can reveal genetic drivers, molecular similarities, and tumor weaknesses that shape new treatments.
AI's potential
Imagine an AI system built only for cancer research—like a ChatGPT for cancer. Doctors and scientists could ask complex questions and receive evidence-based answers. Training AI on decades of cancer-specific data could open entirely new paths for treatment and discovery.
Overcoming data silos
The data to power this vision already exists. But it's siloed across 57 National Cancer Institutes, limited by privacy, regulation, and intellectual property concerns. Federated learning offers a solution. This approach allows AI to train across many centers while keeping patient data secure and independent.
Empowering research with federated learning
Federated learning enables AI to use distributed data without compromising it. CAIA will apply this method to support leading-edge research at every participating center. With access to larger and more diverse datasets, scientists will be able to design, test, and deploy new AI models that push cancer research forward.
Our progress
We're working with our founding cancer centers and partners to launch our first AI model by the end of 2025. Our focus is on accessible data. Learn more about what we've already accomplished.